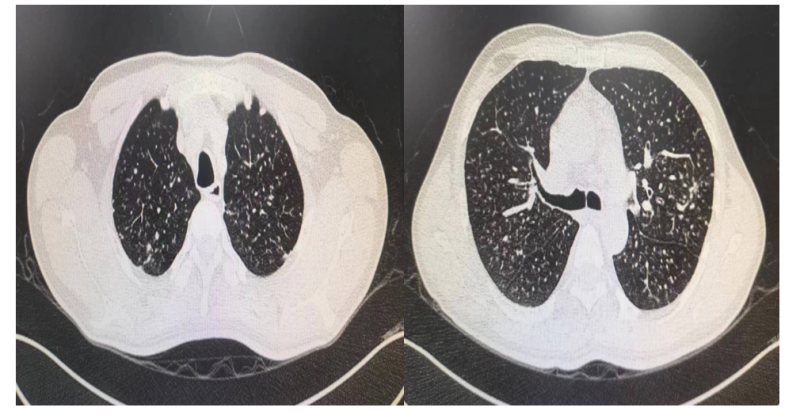

自治区南溪山医院呼吸一区通过大容量肺泡灌洗术实现肺部“大保洁”
发布时间:2024-07-11 16:37
本文来源: 系统
分享到:
近日,广西壮族自治区南溪山医院呼吸与危重症医学科一病区通过大容量肺泡灌洗术,让一名尘肺患者肺部清爽地做了一次"大保洁"。
患者吴某,男性,45岁,因"反复咳嗽1年多,伴气喘3月余"于5月21日就诊南溪山医院呼吸与危重症医学科一区,入院查肺部 CT显示两肺多发异常密度影,考虑职业相关性肺疾病,经追问病史,得知患者从事石头打磨工作多年,结合病史考虑患者肺部病变为尘肺可能性大。经呼吸一区佘巍巍博士团队分析患者病情后,发现患者肺部病变明显,有大容量肺泡灌洗术指征,经与患者详细沟通病情后,患者及家属积极同意配合治疗。
5月28日,经全麻下行气管插管有创机械通气保驾护航下,医护团队经气管插管入镜,予镜下行大容量肺泡灌洗,共灌2500ml,回收1600ml,过程顺利,让患者肺部清爽的做了一次"大保洁"。
图一 肺部CT
图二 大容量肺泡灌洗液情况 第一瓶

图三 大容量肺泡灌洗液情况 第二瓶

图三 大容量肺泡灌洗液情况 第三瓶

图四 术中情况

扫一扫 看病更方便
